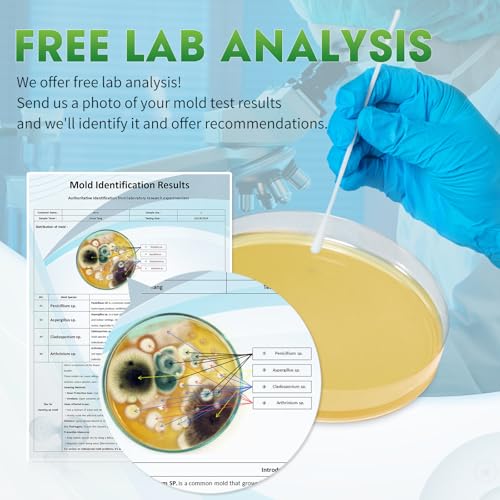
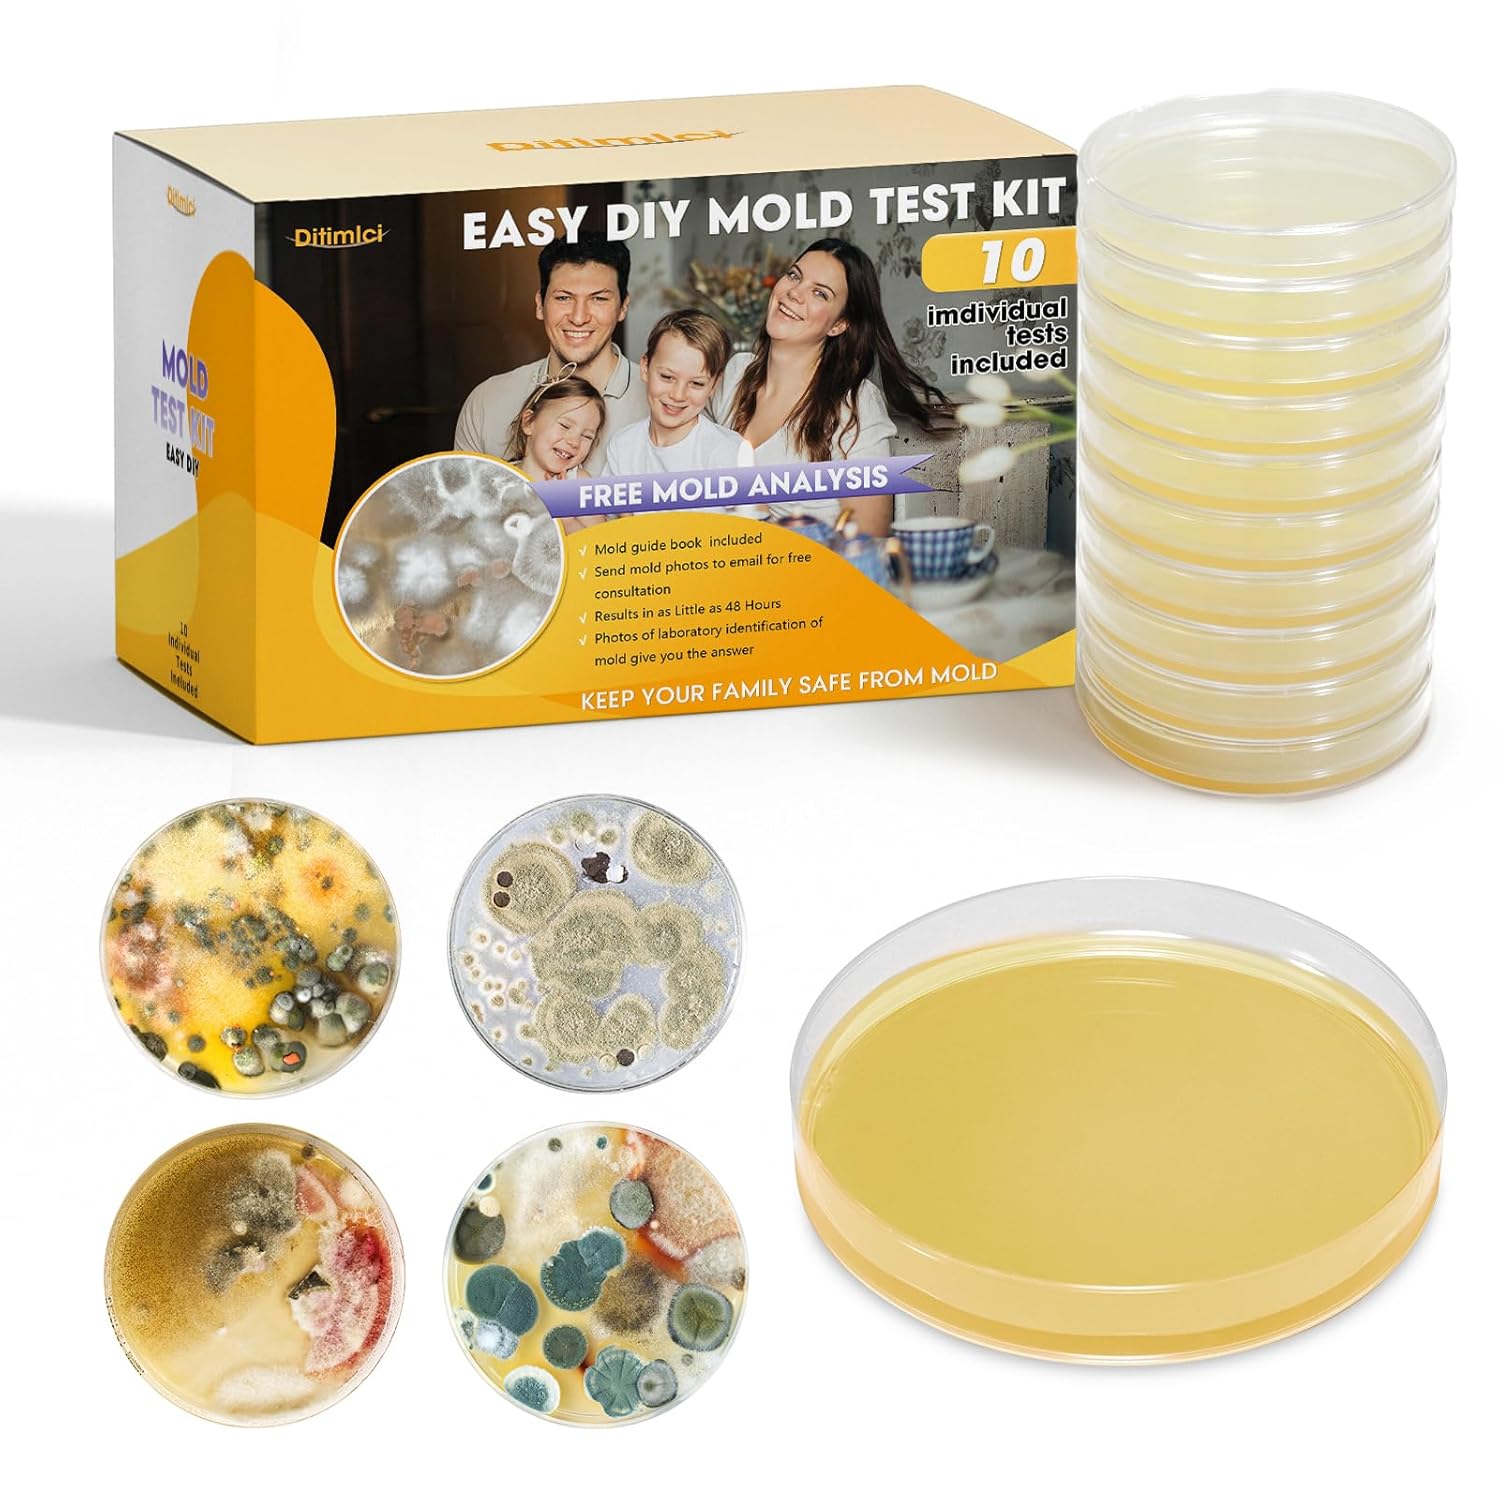

Artículo: AMZ-B0DHDBMLRF
Mold Test Kit for Home with Free Lab Analysis - 10 Simple Detection Tests DIY at Home Mold Air Tester - Test HVAC System,Surface Mold for Home Indoor & Outdoor Air Quality Mold Testing Kits Detector
Style:
10 Pcs

En stock
0.39 kg
Sí
Nuevo
Amazon
- 5 Complete Mold Testing Kit - This DIY home mold test kit includes 5 individual tests, allowing you to conduct thorough and extensive mold assessments throughout your home. Ideal for testing for mold at multiple areas, ensuring no spot is left unchecked
- Tests Indoor Air, HVAC Systems, Cars and Home Physical Surfaces。 It tests for a variety of molds, including common household varieties. Test Test room air,HVAC system,any household surface,home or office, such as walls, showers, cars, sinks, HVAC systems, indoor air and other moldy and moist physical surfaces
- Fast and Reliable mold detector - This mold test kit for home includes a mold identification guide, it delivers quick and reliable results. You can easily identify and understand the type of mold present in your home, enabling prompt and effective action
- Ideal for Home Safety - Our home mold testing kit is Perfect for ensuring your home environment is safe and mold-free. Regular testing helps in maintaining a healthy living space, especially crucial for families with kids or individuals with allergies and respiratory issues
- Discover Household Molds: Test room air, HVAC system, and any household surface in depth. This air mold test kit is designed for home or office use. It is an efficient air mold test kit, and you will see results in as little as 2-4 days. Get five samples from various places and analyze the levels of different molds to assess the environmental situation of your home.
IMPORT EASILY
By purchasing this product you can deduct VAT with your RUT number







.svg)


